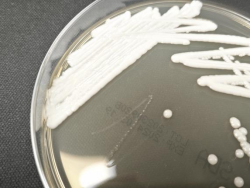
from clipboard

职位推荐
- 珍格医疗-临床销售 15001-20000
- 地奥制药-医药代表 6001-8000
- 普利德医疗-医疗设备销售经理 面议
- 大唐-兼职招商经理 面议
- 景德中药-直营经理 6001-8000
- 安邦医药-省区招商经理 8001-10000
- 恒瑞医药-医药信息沟通专员 6001-8000
- 黄河中药-学术讲师 8001-10000
发布日期:2024-01-19 浏览次数:145
近日,我院感染性疾病中心救治了一名海外输入的播散性多重耐药耳念珠菌病患者。患者为青年男性,因桥脑出血后继发全身多部位复杂性感染,包括被称为“超级真菌“的耳念珠菌。经过感染性疾病中心及多学科联合救治,患者已于近期康复出院。
在华西入院的2月前,患者因“桥脑出血性病变”在北非某国家的国际医疗中心予以内科治疗,并先后行胃造瘘、气管插管、气管切开,因治疗效果欠佳,在入院的1月前,患者回国并在当地医院继续治疗,病情无缓解,并出现高热、意识障碍;随后,患者转入我院并急诊收入感染性疾病中心曲俊彦教授医疗组。
患者入院时发热,呼吸心率增快,神志嗜睡,呼之有反应,不能对答,气管切开状态,双眼向右凝视,完善病原学、影像学等检查,发现该患者同时存在血流、肺部、尿路、胃造瘘口周围及腹腔多部位复杂性感染。该患者除分离出其他难治性泛耐药的病原细菌外,还从胃造瘘口周围感染灶分离出耳念珠菌。耳念珠菌常呈多重耐药,可引起重度感染,可选药物极为有限,治疗困难,容易形成播散性感染。
明确耳念珠菌感染后,医疗组立即对患者进行标准接触隔离措施,并报医院感染管理部。医院感染管理部迅速响应,第一时间到达科室现场指导隔离防控相关措施。治疗过程中,医疗组又从其他感染部位多次分离出耳念珠菌,该菌在对多种抗真菌药物耐药的基础上,迅速对更多药物产生耐药,使得救治方案几经调整优化。
经过感染性疾病中心全科讨论,结合耳念珠菌耐药特点、泛耐药细菌的耐药酶型与致病特点等情况制定联合抗感染治疗方案;针对患者桥脑出血、胃造瘘口周围感染、气管插管等情况,全院消化内科、耳鼻咽喉-头颈外科、康复医学中心、神经外科等多学科通力合作,适时进行内镜下胃造瘘管取出、气管导管周围感染处理、脑出血后期康复等措施,患者体温逐渐恢复正常,意识转清,感染灶缩小,双眼凝视等情况逐步好转。
整个治疗过程异常艰难,需要权衡考虑患者综合情况:患者不仅颅内桥脑出血,而且存在胃造瘘拔管困难;感染控制需尽快去除病灶;此外,还面临长期卧床、外出检查风险高。医疗组在全科及全院多学科通力协作下,对患者进行了个性化动态调整的抗感染治疗、病灶处理、营养支持等综合治疗,患者病情逐渐好转并于2023年底出院。患者目前情况良好,仅有双眼轻度向右凝视,并处于持续恢复中。
耳念珠菌培养照片

耳念珠菌荧光染色照片
耳念珠菌(Candida auris),又称耳道假丝酵母菌,是2009年在一名日本患者的外耳道分泌物中首次发现的真菌,是一种侵袭性真菌。随后,该真菌在全球范围内迅速传播,已被除南极洲外其他六大洲的50多个国家报道,因其多重耐药性、传播性强和病死率高,被称为“超级真菌“,也被世界卫生组织列入对人类健康构成严重威胁的真菌名单。对于此类极为难治的真菌感染,往往需要感染专科医师的专业诊治和多学科合作。
耳念珠菌属于条件致病菌,健康人群对耳念珠菌具有较强的免疫力,即使携带也不会发病,可长期定植在口腔、鼻孔、腋窝、腹股沟和直肠等处,没有明显感染症状,但当机体免疫力低下时,机体内的耳念珠菌大量增殖、过度生长,破坏机体屏障,进而侵犯人体不同组织,引起多种侵袭性感染。耳念珠菌主要通过接触的方式进行传播,如母婴传递、皮肤接触、医疗器械接触、性接触等。耳念珠菌病患者、无症状带菌者、被污染的物品是主要传播来源。耳念珠菌感染患者可出现发热、寒战、咳嗽、呼吸困难、头痛、乏力、伤口红肿、疼痛、血压降低、耳道瘙痒等症状。
300多万优质简历
17年行业积淀
2万多家合作名企业

微信扫一扫 使用小程序

